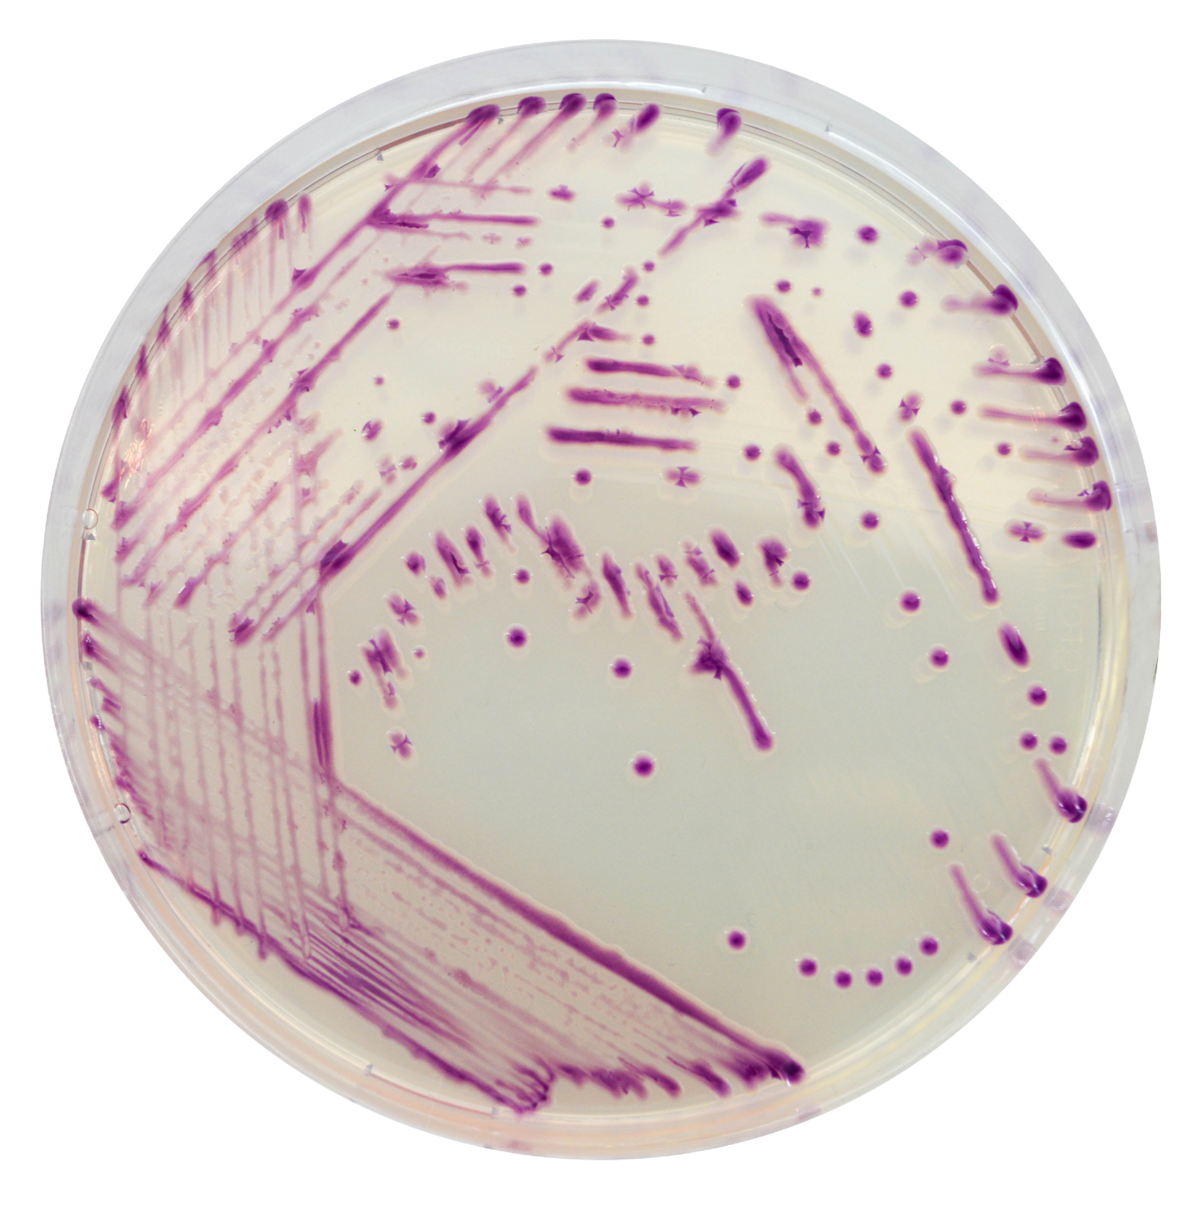

LB082
For Group B Streptococcus (GBS) screening
Package size: 5000 ml
DKK 1.125,00
DKK 3.000,00
Not in stock, delivery 1-2 weeks
Chromogenic medium for the detection of Pasteurellaceae.
The product is composed of a powder base and 2 supplements.
MEDIUM PERFORMANCE:
1. Unique chromogenic media: first and only available specific medium for Pasteurellaceae in the market.
2. Lower workload: contrary to general media like blood agar, CHROMagar™ Pasteurella differentiates the target group from the other bacteria by the a distinctive mauve colony color.
3. Highly selective: most of the environmental flora will be inhibited.
4. Early plate reading: most isolates will have a noticeable colony size after just overnight incubation.
TYPICAL APPEARANCE OF MOCROORGANISMS:
Pasteurellaceae → pink to mauve
E. coli, Coliforms → inhibited, blue to steel blue
In the veterinary field, respiratory infections in cattle herds can cause stunted growth, decline in milk production and death of animals, leading to significant economic losses. Bacteria of the Pasteurellaceaefamily are commensal to the upper respiratory tract of many vertebrate species. Among them, Histophilus somni, Pasteurella multocida and Mannheimia haemolytica are among the main bacteria associated with the pathogenic complex of bovine respiratory diseases. During infection, these species cause complications which can lead to sepsis and death of the animal.
CHROMagar™ Pasteurella was therefore developed to improve the detection of Pasteurellaceae from a bovine respiratory sample (eg. nasal swab, trans-tracheal aspiration (TTA) and lung). This chromogenic medium to aid in qualitative diagnosis allows the detection and isolation of Pasteurellaceae colonies by inhibition or differentiation of the annex flora.
CHROMagar™ Pasteurella medium can also be used for samples from the respiratory tract of mammals such as cats and dogs.